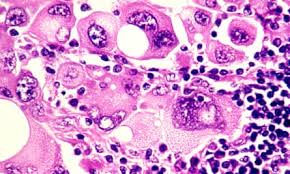

Breaking News
 Owen Report - 10-16-2025 - Gaza Peace Deal Hangs In Balance While Trump Negotiates Peace With Russia
Owen Report - 10-16-2025 - Gaza Peace Deal Hangs In Balance While Trump Negotiates Peace With Russia
 Inflation: Slowly the Middle-Class Dies
Inflation: Slowly the Middle-Class Dies
 The LIES About The Dentist They Don't Want You To Know
The LIES About The Dentist They Don't Want You To Know
Top Tech News
 3D Printed Aluminum Alloy Sets Strength Record on Path to Lighter Aircraft Systems
3D Printed Aluminum Alloy Sets Strength Record on Path to Lighter Aircraft Systems
 Big Brother just got an upgrade.
Big Brother just got an upgrade.
SEMI-NEWS/SEMI-SATIRE: October 12, 2025 Edition
 Stem Cell Breakthrough for People with Parkinson's
Stem Cell Breakthrough for People with Parkinson's
 Linux Will Work For You. Time to Dump Windows 10. And Don't Bother with Windows 11
Linux Will Work For You. Time to Dump Windows 10. And Don't Bother with Windows 11
 XAI Using $18 Billion to Get 300,000 More Nvidia B200 Chips
XAI Using $18 Billion to Get 300,000 More Nvidia B200 Chips
 Immortal Monkeys? Not Quite, But Scientists Just Reversed Aging With 'Super' Stem Cells
Immortal Monkeys? Not Quite, But Scientists Just Reversed Aging With 'Super' Stem Cells
 ICE To Buy Tool That Tracks Locations Of Hundreds Of Millions Of Phones Every Day
ICE To Buy Tool That Tracks Locations Of Hundreds Of Millions Of Phones Every Day
 Yixiang 16kWh Battery For $1,920!? New Design!
Yixiang 16kWh Battery For $1,920!? New Design!
 Find a COMPATIBLE Linux Computer for $200+: Roadmap to Linux. Part 1
Find a COMPATIBLE Linux Computer for $200+: Roadmap to Linux. Part 1
Cancer Dies When You Do THIS
Cancer prevention starts with the diet. Depending on what you eat, you're either starving cancer or feeding it! Discover the best cancer prevention diet and my expert tips to prevent cancer and support the immune system.

 The Right to Try
The Right to Try


